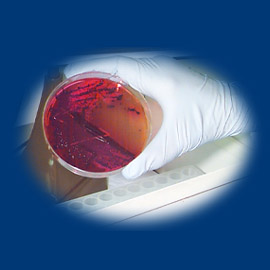
1890

|
 1991 1991
Gov. Jim Edgar appoints Dr. John R. Lumpkin as director, the first African
American to lead the agency.
A new state law requires children to be screened for lead prior to entering kindergarten, preschool, day care or
nursery school. In the first year, about 23,000 children are identified with
lead poisoning. lead prior to entering kindergarten, preschool, day care or
nursery school. In the first year, about 23,000 children are identified with
lead poisoning.
1992
Seven University of Illinois at Urbana-Champaign students are stricken by
meningococcal disease and two die. The Department joins with the university to
vaccinate all undergraduate students against the disease.
1995
 A dozen children become ill and test positive for
E. coli 0157:H7 or have symptoms compatible with the bacteria after
swimming at Rock Cut Beach State Park in Rockford. The Department of Natural
Resources closes the beach and the Department determines that an infected
bather defecating in the lake is the most likely source. A dozen children become ill and test positive for
E. coli 0157:H7 or have symptoms compatible with the bacteria after
swimming at Rock Cut Beach State Park in Rockford. The Department of Natural
Resources closes the beach and the Department determines that an infected
bather defecating in the lake is the most likely source.
 For the first time since 1981 when Illinois' first
AIDS case was recorded, the annual number of reported cases of AIDS decline.
There are 2,186 cases reported in 1995, down 28 percent from the previous year.
The state's cumulative total of AIDS cases stands at 16,375, the sixth highest
state total in the U.S. For the first time since 1981 when Illinois' first
AIDS case was recorded, the annual number of reported cases of AIDS decline.
There are 2,186 cases reported in 1995, down 28 percent from the previous year.
The state's cumulative total of AIDS cases stands at 16,375, the sixth highest
state total in the U.S.
A scorching summer contributes to 702 heat-related deaths in the state, about
three-fourths in Chicago.
1997
 An Office of Women's Health is created in the
Department and places a focus on the special health needs of women. It is one
of just six such offices in the U.S. An Office of Women's Health is created in the
Department and places a focus on the special health needs of women. It is one
of just six such offices in the U.S.
As part of a massive reorganization of how the state delivers human services,
19 programs from the Department, including Maternal and Child Health and WIC,
are moved to the newly formed Department of Human Services. DHS also
consolidates the departments of Mental Health and Development Disabilities,
Alcoholism and Substance Abuse, and Rehabilitation Services, as well as parts
of Public Aid and Children and Family Services.
 The state's infant mortality rate - 8.2 deaths per 1,000
live births - is the lowest ever recorded. The state's infant mortality rate - 8.2 deaths per 1,000
live births - is the lowest ever recorded.
1999
After an outbreak of group A streptococcus in the Chicago area, Gov. George H.
Ryan pledges $500,000 to the Department for the creation of an infectious
disease rapid response team.
 Using sophisticated genetic testing, the Department is able to
positively pinpoint beef served at a Labor Day party in Menard County as the
source of an E. coli 0157:H7 outbreak that sickens more than 300 persons
in three states. Using sophisticated genetic testing, the Department is able to
positively pinpoint beef served at a Labor Day party in Menard County as the
source of an E. coli 0157:H7 outbreak that sickens more than 300 persons
in three states. |
|